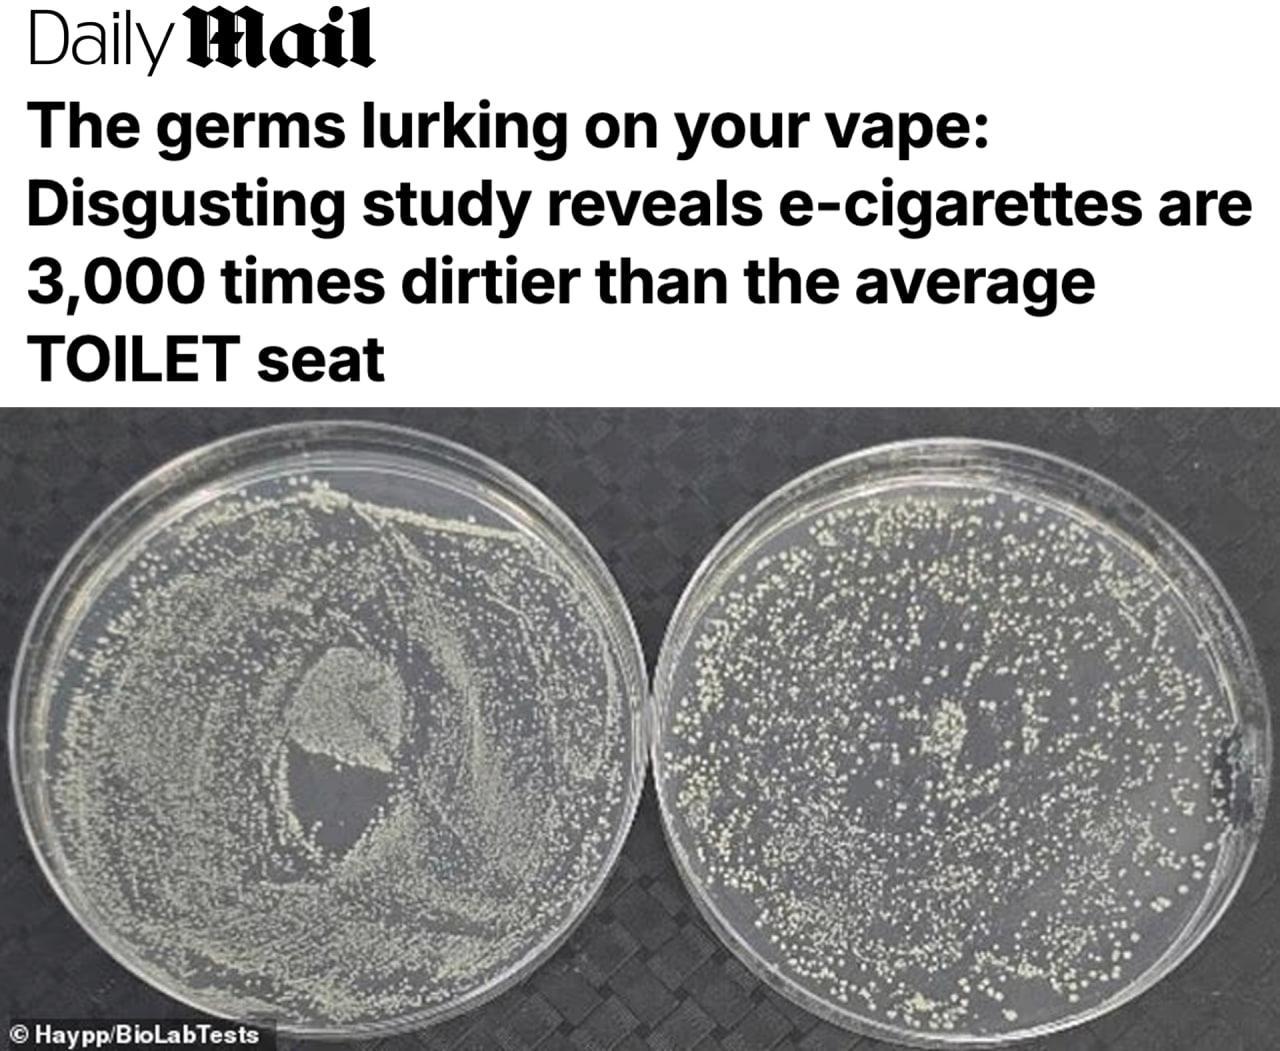
Вейпы в три тысячи раз грязнее сиденья унитаза Теплая и влажная среда мундштука становится плодородной почвой для развития патогенов Ученые выяснили что биологическая активность распространяется и на корпус дуделки пишет Daily Mail Проблема еще и в том что на устройствах образуются биопленки которые позволяют бактериям быть в безопасности Удалить такую гадость с электронной сигареты крайне сложно Покажите этот пост своему парильщику   Подпишитесь на Абзац TG VK Дзен MAX Rutube

20 ноября, 14:00
Учёные обнаружили, что вейпы содержат в 3000 раз больше бактерий, чем унитазы

Беспощадный Банкстер
Вейпы оказались в 3000 раз грязнее унитаза заявили учёные На каждом устройстве живут сотни тысяч бактерий а влажный мундштук становится идеальной средой для их размножения С каждой затяжкой человек вдыхает не только химикаты но и целый коктейль микробов способный вызвать серьёзные заболевания bezposhady
Наука81 день назад

Абзац
Вейпы в три тысячи раз грязнее сиденья унитаза Теплая и влажная среда мундштука становится плодородной почвой для развития патогенов Ученые выяснили что биологическая активность распространяется и на корпус дуделки пишет Daily Mail Проблема еще и в том что на устройствах образуются биопленки которые позволяют бактериям быть в безопасности Удалить такую гадость с электронной сигареты крайне сложно Покажите этот пост своему парильщику Подпишитесь на Абзац TG VK Дзен MAX Rutube
Наука81 день назад


ТОРГОВЫЙ
Мундштуки вейпов могут быть в 3000 раз грязнее унитазов Мундштуки вейпов согласно недавнему исследованию могут быть в 3000 раз грязнее унитазов так как всего за три дня на них могут образоваться колонии стафилококка плесени и кишечных бактерий достигающие 150 тысяч единиц в то время как на сиденье общественного туалета их около 50 bisrub
Наука81 день назад


ТВ Центр | ТВЦ
Вейпы оказались грязнее туалетов в ТРИ ТЫСЯЧИ РАЗ Новые исследования показали что теплая и влажная среда на мундштуке отличное место для размножения микробов Некоторые бактерии могут сильно вредить дыхательным путям подчеркивают ученые из Англии Подписаться на ТВЦ в MAX Пересылайте любителям дуделок
Наука81 день назад


Курск №1
Ученые вейпы в три тысячи раз грязнее чем сиденья унитазов Шокирующее открытие о микробах на мундштуках электронных сигарет сделали специалисты из лаборатории BioLabTests Оказалось что причина в теплой и влажной среде В ней микроорганизмы начинают активно размножаться Как только человек решает попарить микробы активно перебегают в его организм Многие из них могут причинить сильный вред дыхательной системе заявили специалисты Подпишись на Курск 1
Наука81 день назад


Dagpravda | Здоровье
Вейпы в 3 тыс раз грязнее сиденья унитаза выяснили учёные Тёплая и влажная среда мундштука быстро может стать рассадником патогенов Об этом пишет Daily Mail со ссылкой на лабораторию BioLabTests Подробности из материала на третьи сутки использования тестового вейпа количество грибков и бактерий увеличилось в тысячи раз биологическая активность была обнаружена и в корпусе устройства исследователи предполагают что на устройствах могут образовываться биоплёнки которые трудно удалить многие из микроорганизмов найденных на вейпе обычно присутствуют на коже человека и в окружающей среде эксперты призывают протирать курительные устройства теми же средствами что и смартфоны которые тоже являются переносчиками микробов Напомним Путин поддержал идею полного запрета продажи вейпов в России В правительстве подготовили поправки для подобных ограничений в регионах
Наука81 день назад

Новости Москвы
Вейпы в 3 000 раз грязнее сиденья унитаза ученые Теплая и влажная среда мундштука быстро может стать рассадником патогенов Ученые выяснили что биологическая активность распространяется и на корпус курилки
Наука81 день назад


Прямой Эфир • Новости
Вейпы оказались в 3000 раз грязнее унитазов По данным исследования уже через три дня мундштук электронной сигареты превращается в настоящий рассадник микробов с колониями стафилококка плесени и кишечных бактерий до 150 тысяч единиц Для сравнения на сиденье общественного туалета их около 50 Прямой эфир
Наука81 день назад


PostNews
Вейп в 3000 раз грязнее сиденья унитаза Живите с этим Уже через три дня использования мундштук вейпа покрывается около 150 тыс бактерий и грибков Это в 3000 раз больше чем находят на обычном общественном туалете показало новое исследование BioLabTests Дело в том что теплый и влажный мундштук идеальный инкубатор для микробов Вейпы собирают всю грязь с рук карманов столов и потом отправляют ее прямо в рот Что скажете какая мерзость хорошо что я не курю это было очевидно и что мне теперь делать Подписывайтесь на PostNews в MAX
Наука81 день назад

Владивосток и точка 🔴
Вейпы оказались в 3000 раз грязнее унитазов По данным исследования уже через три дня мундштук электронной сигареты превращается в настоящий рассадник микробов с колониями стафилококка плесени и кишечных бактерий до 150 тысяч единиц Для сравнения на сиденье общественного туалета их около 50 Подпишись vdk i tochka
Наука81 день назад

Похожие новости



+6



+2



+5



+10



+6



+2

Проблемы с полигоном Щелба: кассационная жалоба владельца и пожар на свалке в Новосибирске
Происшествия
16 часов назад


+6
В Ленинградской области ликвидирована нарколаборатория по производству метадона
Происшествия
12 часов назад


+2
Правительство России принимает меры по регулированию водохранилищ в условиях повышенной водности
Общество
11 часов назад


+5
В Псковской области стартует профилактическое мероприятие по снижению рисков пожаров
Происшествия
13 часов назад


+10
В Петропавловске Камчатском возбуждено дело о мошенничестве с кредитной картой на имя покойного
Происшествия
11 часов назад


+6
Минстрой выявил более 40 нарушений на строительных площадках Северной Осетии
Происшествия
14 часов назад


+2